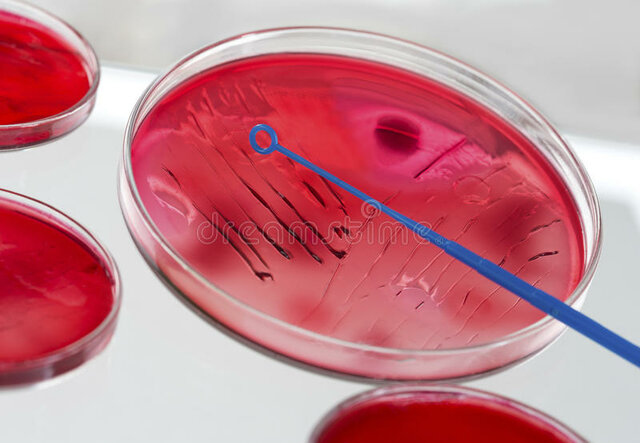
Inoculación

-
En Constantinopla, Giacomo Pylarini empezó a infectar a niños con pequeñas dosis de viruelas para evitar infecciones más grandes, sentando el precedente de la vacunación.
En Constantinopla, Giacomo Pylarini empezó a infectar a niños con pequeñas dosis de viruelas para evitar infecciones más grandes, sentando el precedente de la vacunación. -
 Oriundo de Francia, el químico Louis Pasteur, calentando alimentos hasta matar los microbios, desarrolló el proceso de pasteurización el cual se iría refinando con el pasar de las décadas y siglos
Oriundo de Francia, el químico Louis Pasteur, calentando alimentos hasta matar los microbios, desarrolló el proceso de pasteurización el cual se iría refinando con el pasar de las décadas y siglos -
 Friedrich Miescher, biólogo nacido en Suiza, logró aislar por primera vez cierto compuesto que llamó nucleína, la cual contiene ácido nucleico.
Friedrich Miescher, biólogo nacido en Suiza, logró aislar por primera vez cierto compuesto que llamó nucleína, la cual contiene ácido nucleico. -
 El químico estadounidense, Thomas Hunt Morgan, descubre que los llamados genes residen en los cromosomas
El químico estadounidense, Thomas Hunt Morgan, descubre que los llamados genes residen en los cromosomas -
 El profesor de bacteriología del Hospital St. Mary's de Londres, descubre por accidente la penicilina al ver cómo cierto moho mataba bacterias que había cultivado.
El profesor de bacteriología del Hospital St. Mary's de Londres, descubre por accidente la penicilina al ver cómo cierto moho mataba bacterias que había cultivado. -
 Los investigadores Oswald Theodore Avery, Colin MacLeod y Maclyn McCarty, determinan que el ADN se trata de un material hereditario y establecen una teoría al respecto.
Los investigadores Oswald Theodore Avery, Colin MacLeod y Maclyn McCarty, determinan que el ADN se trata de un material hereditario y establecen una teoría al respecto. -
 James Watson y Francis Crick proponen el modelo de doble hélice del ADN complementaria y antiparalela. Dando el primer paso a la genética moderna.
James Watson y Francis Crick proponen el modelo de doble hélice del ADN complementaria y antiparalela. Dando el primer paso a la genética moderna. -
 Dirigido por James Wtason y financiado por miles de millones de dólares, la meta de este proyecto era identificar y secuenciar todos los genes del genoma humano. Completando la secuencia en el año 2003.
Dirigido por James Wtason y financiado por miles de millones de dólares, la meta de este proyecto era identificar y secuenciar todos los genes del genoma humano. Completando la secuencia en el año 2003. -
 Se logra clonar por primera vez una especie en peligro de extinción (el banteng) y otras especies como el caballo, venados y mulas, dando el primer paso a la clonación de animales.
Se logra clonar por primera vez una especie en peligro de extinción (el banteng) y otras especies como el caballo, venados y mulas, dando el primer paso a la clonación de animales.
Looking for a timeline maker?
Create timelines for projects, roadmaps, history, lessons, legal cases, and stories with Timetoast. Timetoast is a timeline maker for work, school, research, and stories.